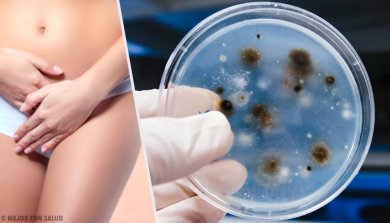
Infecções vaginais: tipos e causas

Infecções vaginais: tipos e causas
As infecções vaginais podem causar alterações tanto na área vaginal quanto na vulva. É importante que você seja informada sobre quais são as infecções vaginais mais comuns e as causas que tendem a desencadeá-las com mais frequência. Desta forma, será mais fácil evitá-las.
Causas das infecções vaginais
Algumas mulheres sofrem com esse problema mais frequentemente. No entanto, isso não implica necessariamente falta de higiene, maus hábitos ou práticas sexuais de risco.
1. Não trocar os preservativos
Embora não esteja diretamente ligado ao aparecimento de infecções vaginais, uma de suas causas é fazer sexo anal e vaginal sem trocar o preservativo.
O que acontece neste caso é que as bactérias fecais se espalham do ânus para a vagina. Para evitar o problema, é importante mudar o preservativo se você quiser realizar ambas as práticas sexuais.
2. Antibióticos

Isso parece contraditório porque, em teoria, os antibióticos procuram eliminar os agentes causadores das doenças. No entanto, você pode ter infecções vaginais porque esse tipo de droga afeta tanto as bactérias benéficas (flora bacteriana) quanto as bactérias nocivas, o que nos torna mais suscetíveis ao desenvolvimento de infecções fúngicas.
3. Alteração hormonal
As alterações hormonais também podem causar infecções fúngicas vaginais devido ao aumento do estrogênio no organismo. Os momentos em que ficamos mais suscetíveis são durante a gravidez, quando estamos fazendo terapia hormonal ou durante a menopausa.
4. Níveis elevados de glicose no sangue
A vontade de comer alimentos doces não é exclusiva dos humanos, as leveduras também o adoram, e é por isso que existe uma conexão entre diabetes e infecções por fungos. É importante seguir uma dieta pobre em gordura e açúcar, tanto para melhorar a saúde quanto para prevenir certas doenças.
No caso da diabetes, certifique-se de manter seus níveis de glicose dentro da faixa fisiológica para evitar infecções vaginais, entre outros desconfortos.
5. Usar roupas feitas de materiais sintéticos
Como todos sabemos, ambientes quentes, úmidos e mal oxigenados são os locais onde as bactérias e os fungos que causam as infecções se desenvolvem mais facilmente. Nesta categoria encontramos:
- Roupas muito justas (calças, shorts, etc.).
- Roupa intima de material sintético.
- Calças em leggings ou lycra ou outros tecidos que não permitam uma boa transpiração.
Todos eles criam um ambiente perfeito para o desenvolvimento de micro-organismos na área genital, principalmente a levedura. Se você gosta de calças apertadas, tente tirá-las ou trocá-las a cada 10 horas. Além disso, é recomendável que você verifique a composição e escolha roupas feitas com ao menos 50% de algodão.
Tipos de infecções vaginais
Nem todas as infecções vaginais são as mesmas. Cada uma tem características diferentes e deve ser tratada de uma maneira particular.
Micose vaginal ou infecção fúngica
Este é o caso da candidíase. As infecções fúngicas são as mais comuns. Especificamente, a candidíase geralmente provoca:
- Corrimento vaginal espesso,
- Vermelhidão na vagina e vulva,
- Coceira.
Seu tratamento é simples na maioria dos casos. Você pode comprar óvulos ou cremes que combatem o problema em qualquer farmácia.

Vaginose bacteriana
É comum em mulheres em idade reprodutiva. A vaginose aumenta o risco de desenvolver doenças sexualmente transmissíveis. É caracterizada por:
- Dor ao urinar.
- Coceira e dor vaginal.
- Corrimento descolorido ou branco.
- Corrimento vaginal com cheiro de “peixe” após a relação sexual.
Infecções vaginais por tricomoníase
É causada por um agente microbiano chamado Trichomonas vaginalis. Este tipo de infecção deve ser tratado com antibióticos, uma vez que se espalha através da relação sexual. Suas características são:
- Cheiro de mofo.
- Corrimento amarelo esverdeado.
- Queimação vaginal e coceira.
Clamídia
É uma infecção sexualmente transmissível. Além de ser capaz de afetar a área genital, também pode causar outras doenças, como artrite, pneumonia ou conjuntivite. Dá origem a maus odores no corrimento vaginal, que nestes casos assume uma cor esbranquiçada.
Infecção vaginal do tipo viral

Este tipo de infecção é causada pelo vírus herpes simples. Além da irritação, aparecem bolhas na área genital que se transformam em úlceras.
Outra razão pela qual esse tipo de infecção aparece é o vírus do papiloma humano, que causa verrugas genitais. Em ambos os casos, é importante consultar um médico.
Agora que você sabe quais são as infecções vaginais mais comuns, suas causas e sintomas, é hora de começar a cuidar melhor de si mesma (se ainda não o faz). Lembre-se de que, em muitos casos, a prevenção é o melhor remédio que existe.
Todas as fontes citadas foram minuciosamente revisadas por nossa equipe para garantir sua qualidade, confiabilidade, atualidade e validade. A bibliografia deste artigo foi considerada confiável e precisa academicamente ou cientificamente.
- Brotman, R. M. (2011). Vaginal microbiome and sexually transmitted infections: An epidemiologic perspective. Journal of Clinical Investigation. https://doi.org/10.1172/JCI57172
- Mashburn, J. (2012). Vaginal Infections Update. Journal of Midwifery and Women’s Health. https://doi.org/10.1111/j.1542-2011.2012.00246.x
- Rosenfeld, J. A. (2009). Vaginitis. In Handbook of Women’s Health, Second Edition. https://doi.org/10.1017/CBO9780511642111.013
- Aydin, A., Ahmed, K., Zaman, I., Khan, M. S., & Dasgupta, P. (2015). Recurrent urinary tract infections in women. International Urogynecology Journal. https://doi.org/10.1007/s00192-014-2569-5
- Fidel, P. L., Jr, Cutright, J., & Steele, C. (2000). Effects of reproductive hormones on experimental vaginal candidiasis. Infection and immunity, 68(2), 651–657. https://doi.org/10.1128/iai.68.2.651-657.2000
Este texto é fornecido apenas para fins informativos e não substitui a consulta com um profissional. Em caso de dúvida, consulte o seu especialista.